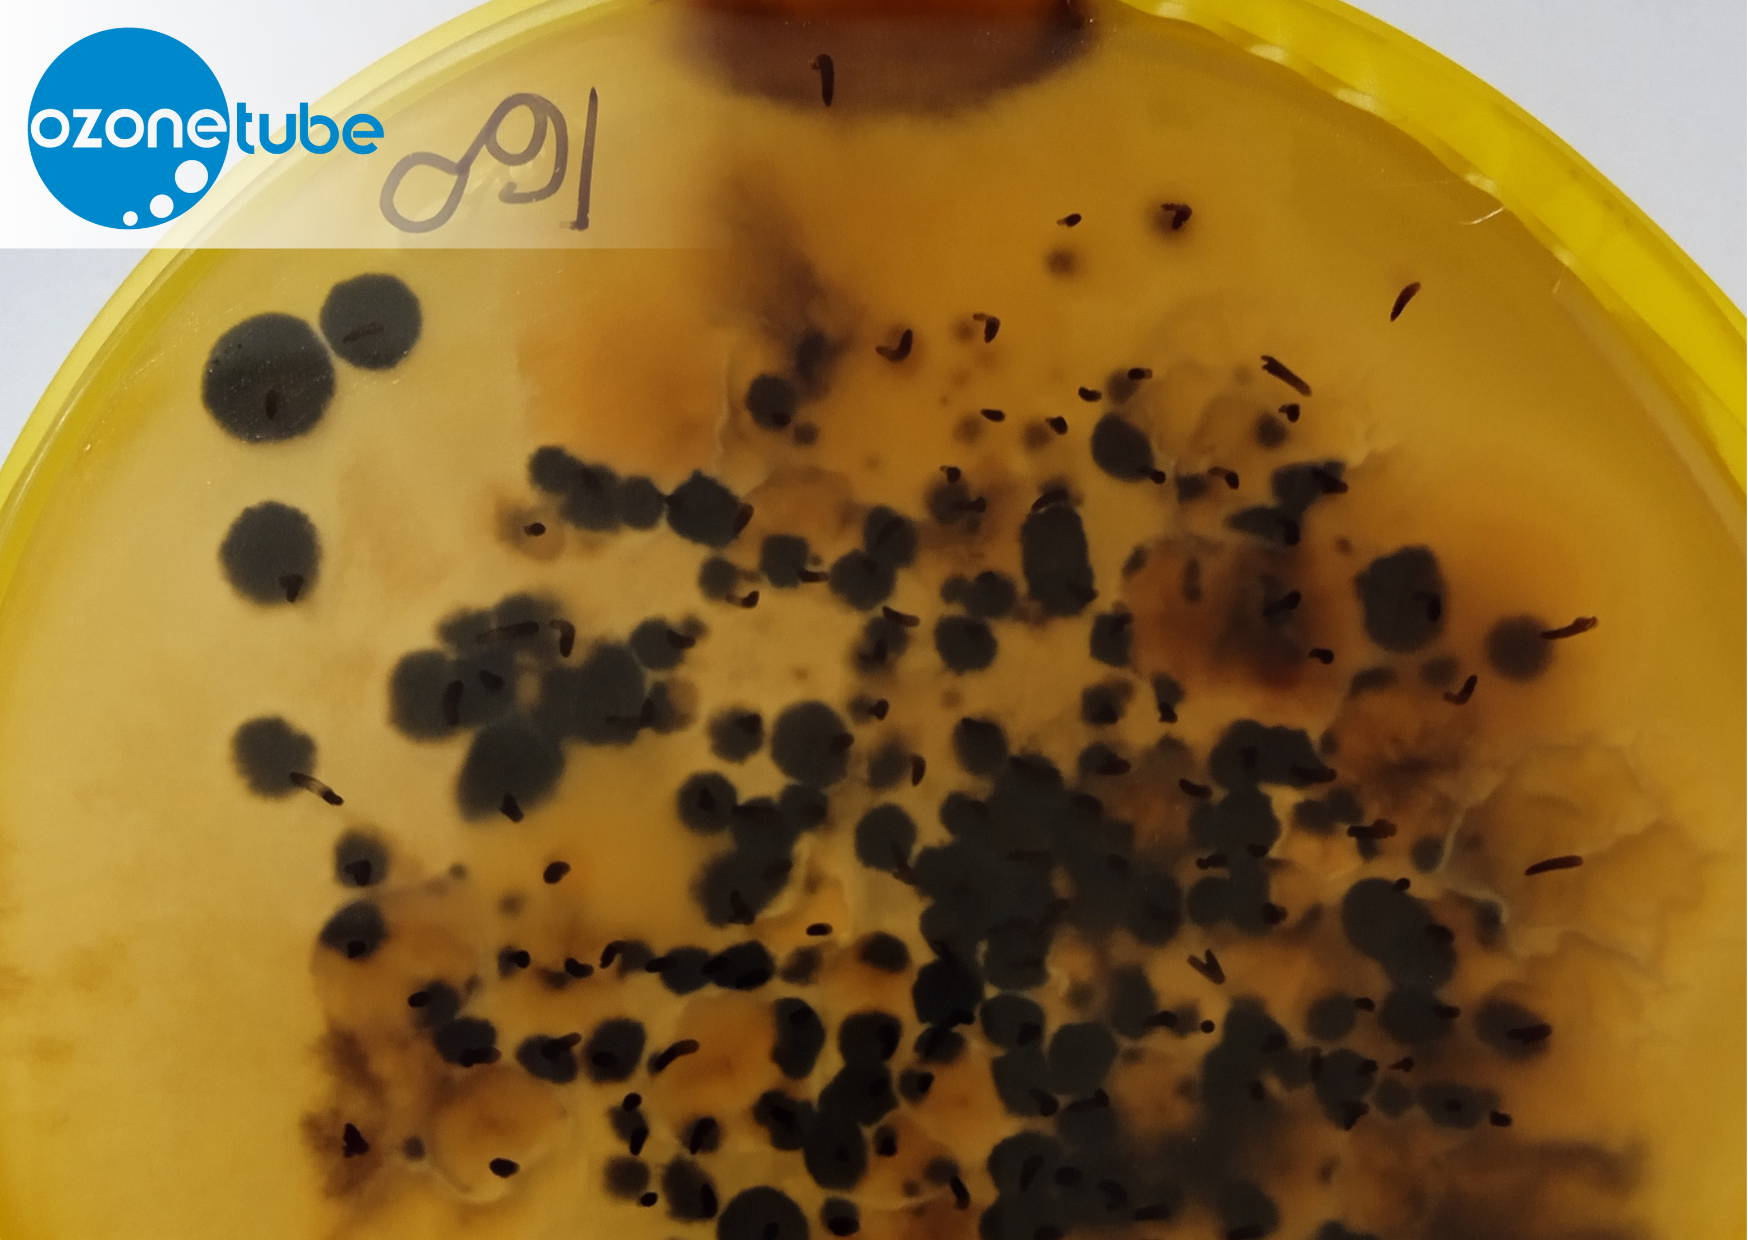
ozonetube, ozonowanie przemysłowe, czy ozonowanie jest bezpieczne, pleśń, jakie stężenie ozonu jest bezpieczne, jak usunąć zapach, ile czasu wietrzyć po ozonowaniu, ozonowanie hybrydowe ozonetube, ozonowanie przemysłowe, czy ozonowanie jest bezpieczne, pleśń, jakie stężenie ozonu jest bezpieczne, jak usunąć zapach, ile czasu wietrzyć po ozonowaniu, ozonowanie hybrydowe

Zapewniamy naszym pociechom najlepszą żywność, zabawki, ubrania, a nawet zajęcia wspierające rozwój – prawdopodobnie część zajęć odbywa się w domu lub online. Wydawać by się mogło, że to głównie miejsca takie jak żłobek/przedszkole/szkoła trzeba najbardziej kontrolować, bo w domu jest przecież bezpiecznie. Jednak wraz z naszymi dziećmi, w otoczeniu domowym znajdują się zanieczyszczenia i drobnoustroje, które mogą szybko dostać się do organizmów dzieci (zwłaszcza, gdy nasi najbliżsi spędzają dużo czasu w tylko z pozoru odpowiednich warunkach). Jako odpowiedzialni rodzice nie możemy zapominać o tym, że szkodliwe mikroorganizmy w najbliższym otoczeniu mogą negatywnie wpływać na stan zdrowia, a co gorsze - skutecznie zaburzać rozwój naszych dzieci. Jednym z najpoważniejszych zagrożeń, które może stać się przyczyną nieprawidłowości rozwojowych jest oddziaływanie toksycznych pleśni.
Pleśń jest bardzo zdradliwa ze względu na to, że wbrew temu, jak powszechnie ją sobie wyobrażamy – wcale nie musi być widoczna w formie kolorowego nalotu na ścianie. Dorosła forma grzybów strzępkowych (pleśni) może być ukryta przed naszym wzrokiem w ciemnych i wilgotnych miejscach, do których nie mamy dostępu lub rzadko zaglądamy.
Badania epidemiologiczne wykazały istotny związek między narażeniem na mykotoksyny a zaburzeniami ze spektrum autyzmu [1], które obecnie dotykają około 1 na 44 dzieci [2]. Zaobserwowano niezdolność do stania na palcach, niezdolność do chodzenia w linii prostej z zamkniętymi oczami, utratę pamięci krótkotrwałej, zmienione opóźnienie odruchu mrugania, zaburzenia pamięci werbalnej, a także problemy z rozróżnianiem kolorów i czasem reakcji [3, 4]. Inne badania pokazują, że pacjenci, którzy byli narażeni na pleśń, byli upośledzeni w zakresie różnych wskaźników poznawczych, w tym uczenia się werbalnego, pamięci wzrokowo-przestrzennej, szybkości psychomotorycznej i funkcjonowania emocjonalnego [5]. Jeden z ekspertów zajmujący się tematem pleśni - Michael A. Pinto, wspomina również o trzykrotnie większym ryzyku zachorowania na astmę niemowląt, które miały rozległy kontakt z pleśnią w ciągu pierwszego roku życia [6].

Przy użyciu systemu ozonowania hybrydowego™ oraz specjalistycznych badań, zaoszczędzimy zasoby finansowe związane bezpośrednio z negatywnym oddziaływaniem pleśni – konsultacjami lekarskimi, lekami, itp. czy szukaniem (jeszcze początkowo nieznanej) przyczyny. Wiemy jednak, że koszty materialne schodzą na dalszy plan w porównaniu z późniejszymi konsekwencjami związanymi z troską o podopiecznych. Nieprawidłowy rozwój dzieci, szukanie przyczyn nawracających problemów zdrowotnych, niepewność i brak poczucia bezpieczeństwa sprawiają, że opiekunowie zrobią wszystko, aby przywrócić swoje dzieci (oraz samych siebie) do równowagi. Dzięki zastosowaniu ozonowania hybrydowego™ brak poczucia stabilności psychicznej i niepokój związany z działaniem niewidocznych wrogów odejdzie w zapomnienie.
Już przeszło 2400 lat temu Hipokrates, od którego imienia nazwana jest przysięga lekarska stwierdził, że lepiej zapobiegać niż leczyć. W świetle badań naukowych, konsekwencje ekspozycji dziecka na pleśń mogą rzutować na jego całe przyszłe życie. Nie warto bagatelizować objawów kosztem naszych najbliższych. Lepiej zapobiegać oddziaływaniu zarodników pleśni lub jeśli problem już istnieje – niezwłocznie usunąć jego źródło.
Natomiast bardziej problematyczne są zarodniki pleśni. Ze względu na swój mały rozmiar mogą one wędrować w strumieniach powietrza i rozsiewać się nawet do 100 metrów od źródła podobnie jak dmuchawce. Następnie takie „nasiono” będzie ukryte czekać na dogodne warunki do „wykiełkowania” i założenia nowej kolonii. Żeby spory (zarodniki pleśni) mogły swobodnie egzystować i czekać na dogodny moment do rozwoju, matka natura wyposażyła je w niebezpieczne dla człowieka toksyny, które pełnią funkcję ochronną dla zarodników (“dzieci”) pleśni. Właśnie toksyny grzybów, zwane mykotoksynami, negatywnie oddziałują na rozwój naszych najmłodszych członków rodziny, zwiększając ryzyko zaburzeń procesów poznawczych, które się dopiero u nich kształtują.
Nawet na tak poważny problem, jak oddziaływanie toksyn pleśni istnieje skuteczne rozwiązanie. Jest nią ozonowanie hybrydowe™ – autorski system dezynfekcji, który łączy kilka elementów - zastosowanie wysokiego stężenia ozonu, zamgławiania dedykowanym roztworem chemicznym, mechanicznego czyszczenia i badań laboratoryjnych, co daje najwyższą kontrolę i skuteczność w walce z pleśnią, jej zarodnikami i innymi patogenami. Ważnym aspektem tej metody jest to, że w porównaniu do innych technik jest w stanie dokładnie zdezynfekować całe pomieszczenia wraz ze wszystkimi możliwymi zakamarkami. Ponadto, rozwiązanie to jest przystosowane do użycia w przewodach wentylacyjnych, gdzie dezaktywuje rozwijające się tam zarodniki pleśni, które z łatwością wraz z przepływem powietrza mogą rozprzestrzenić się po naszych pomieszczeniach.
Więc jeśli jesteś rodzicem, chcesz być pewna/y, że Twoje dzieci mają odpowiednie warunki do rozwoju lub jeśli borykasz się z nawracającą pleśnią – nie zwlekaj i skonsultuj się ze specjalistą. Na podstawie wywiadu razem ustalicie, jakie działania podjąć, a w razie potrzeby – zbadacie, czy środowisko Twoje i Twoich pociech jest przyjazne pod względem obecności szkodliwych mikroorganizmów. Z pewnością skorzystają na tym wszyscy mieszkańcy domów i mieszkań.
Aby zapobiegać działaniu toksyn pleśni, zalecamy:


Rozwój jest dążeniem, które towarzyszy człowiekowi od zawsze. Można powiedzieć, że jest on niekończącą się ścieżką, którą przez całe życie wytyczamy sobie na różnych płaszczyznach. Szczególnie ważny jest on w trakcie pierwszych kilkunastu lat życia, kiedy trzeba go skrupulatnie wspomagać i pielęgnować. Rodzic w tym czasie przyjmuje podwójną odpowiedzialność, ponieważ oprócz podstawowej opieki i spełniania bieżących potrzeb dziecka, musi jeszcze zadbać, aby otoczenie, w którym dziecko będzie rozwijać się przez najbliższe lata, było sprzyjające.
6 czerwca 2023 r.
Autorzy:
Witold Adamkiewicz, CTO Ozonetube®, kierownik badań
dr inż. Witold Adamkiewicz
Doktor chemii, pasjonat nauki doświadczony w pracach naukowych w kraju i za granicą. W Institute for Basic Science, Center for Soft and Living Matter
w Korei Południowej badał wyładowania koronowe, które są podstawową metodą wydajnego generowania ozonu.
Autor macierzy oraz kalkulatora ozonowania i innych praktycznych narzędzi dla osób wykorzystujących ozon w usługach i przemyśle.Jego pasją są kuchnie świata, cybernetyka, nowe technologie, szczególnie wykorzystanie ozonu w biznesie.
Ozonowanie mieszkania przed sprzedażą. Usuń zapachy, bakterie, grzyby i pleśnie
Dobry flipper musi kupić lokal tanio, sprawnie go odświeżyć i sprzedać szybko z jak najwyższą marżą. W tym działaniu istotny jest czas, aby zainwestowane pieniądze szybko odzyskać i móc realizować kolejne inwestycje. Owszem, niektórzy fliperzy obracają lokalami za pieniądze innych inwestorów, ale mechanizm działania jest taki sam. W związku z tym, że wiele mieszkań, czy domów przeznaczanych na sprzedaż nie podlega remontowi, fliperzy i agenci nieruchomości coraz chętniej sięgają po ozonowanie hybrydowe w celu uzyskania szybkiego efektu odświeżenia lokalu w niskiej cenie. Ozonowanie to naturalny proces oczyszczania występujący w naturze - zjawisko występuje w czasie burzy w momencie, gdy piorun wytwarza ozon (potrójny tlen). Dzięki temu oczyszcza on powietrze, usuwa zapachy i dezynfekuje. Ozonetube®, każdego dnia przenosi to zjawisko przyrodnicze do wnętrz budynków – biur, sklepów, magazynów, a także wspomnianych mieszkań i domów na sprzedaż czy wynajem. Ozonowanie jest naturalną i skuteczną formą dezynfekcji i usuwania uciążliwych zapachów zwierząt, papierosów i stęchlizny. Usuwa także alergeny, grzyby, pleśnie i bakterie. „Sucha burza” oczyszcza, zatem wnętrza nieruchomości, w których pracujemy i mieszkamy, dzięki czemu niskim kosztem, w ciągu kilku godzin możemy osiągnąć nową świeżość.
Jakie efekty daje ozonowanie mieszkania?
Fliperzy, agenci i pośrednicy nieruchomości coraz częściej korzystają z ozonowania hybrydowego, żeby szybko i tanio pozbyć się śladów użytkowania pozostawionych przez poprzednich właścicieli, czy lokatorów. Dodam, że zapachy w mieszkaniach mogą być różne: od papierosów, od zwierząt (alergeny) od poprzednich lokatorów (starsi ludzie, a nawet menele). W ogłoszeniach lokali na sprzedaż czy wynajem, coraz częściej odnotowuje się czy w lokalu palono papierosy lub przebywały zwierzęta. Wiele osób jest uczulonych na sierść zwierząt, więc taki lokal automatycznie wypada z kręgu ich zainteresowań. Agenci opowiadali często, że wprowadzali potencjalnych kupujących do pustych od kilku lat mieszkań i zaczynali oni od razu kichać, mówiąc „tu był kot, nie będziemy tego oglądać” - i z transakcji nici. Zapach papierosów, albo zwierząt unoszący się w lokalu stanowi, zatem nierzadko problem w znalezieniu zainteresowanego nabywcy czy najemcy i jest to istotny czynnik przy sprzedaży lokali. Remont to drogie rozwiązanie rzędu kilkudziesięciu tysięcy złotych, dlatego właściciele nieruchomości, fliperzy albo agenci nieruchomości nie decydują się na takie wydatki, jeśli nie muszą. Kilkukrotnie zdarzyło się nam usunąć zapach papierosów, który unosił się w mieszkaniu, w którym przeprowadzono remont! Nowe ściany, nowa farba i tapety, a nawet nowy pokój dla noworodka przeszły zapachem papierosów. Rodzice - nowi właściciele mieszkania byli zrozpaczeni. Jak, zatem niskim kosztem usunąć przykre zapachy i drobnoustroje? Wysokie stężenie ozonu w ciągu kilku godzin potrafi usunąć nieprzyjemne zapachy w sposób trwały. Nie jest to, zatem chwilowa „przykrywka” na czas sprzedaży lokalu. Co więcej, ozonowanie oprócz zapachów usuwa także bakterie, wirusy, a nawet grzyby! W związku z tym, da się wydezynfekować i usunąć wszelkie elementy, które mogą utrudnić normalne funkcjonowanie nowemu nabywcy. Ozonowanie hybrydowe szybko daje efekt ogromnej świeżości - jest czysto pachnąco i świeżo w powietrzu. Ponadto, zastosowane ozonowanie przy sprzedaży lub wynajmie lokalu można przekłuć w atut. Jak? Przed i po każdym ozonowaniu jest możliwość pobrania próbek w celu laboratoryjnego przebadania skuteczności przeprowadzonego procesu. Ozonetube® wydaje certyfikaty potwierdzające ozonowanie i naklejki potwierdzające przeprowadzenie ozonowania w danym lokalu. Fliper lub agent może wykorzystać to, jako atut przy sprzedaży lokalu, przedstawiając kupującemu wyniki badań i certyfikat ozonowania hybrydowego™. A co z pokojem noworodka? Zespół Ozonetube® usunął zapach papierosów w wyremontowanym mieszkaniu trwale już w 12 godz.
Po co ozonować lokal na sprzedaż?
Kamil Krupicz z agencji nieruchomości Wood&Stone postanowił w celu odświeżenia mieszkania zlecić ozonowanie w jednym z mieszkań w bloku na Sadybie. Obecny właściciel posiadał koty, a dla Kamila istotne było, żeby nowy kupujący obejrzał sobie mieszkanie w komfortowych warunkach i nie wyczuł, że mieszkały tu również zwierzęta. Ściany w 3 pokojach były w tapecie i boazerii, a wszystkie te zapachy weszły w struktury okładzin. Remont mieszkania, wymiana tapet, ściągniecie boazerii i malowanie ścian nie wchodziły w grę, bo wymagałoby to zbyt dużych nakładów finansowych. Agent zdecydował się na ozonowanie hybrydowe z Ozonetube®. Dodatkowo, zostawiliśmy otwarte drzwi od lodówki, w celu wywietrzenia i dezynfekcji jej wnętrza. Kamil po ozonowaniu stwierdził, że czystość powietrza faktycznie była jak po porannej burzy. Nie było przykrych zapachów i naprawdę czuć było świeżość – zarówno w mieszkaniu, jak i w lodówce. Gdy przychodzili potencjalni kupujący nie mówili nic na temat przykrych zapachów, a mieszkanie sprzedało się w ciągu tygodnia. Rozmowę z Kamilem Krupiczem z Wood & Stone możesz obejrzeć tutaj >> https://www.woodandstone.com.pl/partnerzy
Czy ozonowanie mieszkania jest bezpieczne?
Po okresie pandemii ozonowanie, podobnie jak dozowniki z płynem do dezynfekcji rąk, zostało na stałe w wielu sektorach gospodarki, jako standard. W branży nieruchomości przykładowo przeprowadza się je w hotelach, domkach letniskowych, i to każdorazowo po każdym gościu! Wiele osób pyta czy ozonowanie jest bezpieczne? A inna część osób uważa, że ozonowanie nie działa. Jeżeli robi się to zbyt małą mocą, to może nie być żadnego efektu lub może być on symboliczny. Wyobraźmy sobie, że chcielibyśmy ugotować zupę w garnku podgrzewanym ogniem z zapalniczki - też doszlibyśmy do wniosku, że ogień nie działa. Ozonowanie działa, jeśli proces przeprowadzi się z właściwą mocą ozonu i odpowiednio długo się ją utrzyma. Dobrze przeprowadzony zabieg jest skuteczny i bezpieczny! Najpopularniejszym i zarazem najbardziej zwodniczym współczynnikiem jest określanie wydajności ozonatorów w gramach na godzinę (g/h) produkowanego ozonu. Parametr ten ze względu na niestabilną naturę ozonu jest w zasadzie niemożliwy do bezpośredniego zmierzenia i może zostać jedynie oszacowany na podstawie stężenia ozonu w strumieniu powietrza wylatującego z ozonatora. Tak zdefiniowana wielkość, będąca głównym i często jedynym parametrem opisującym wydajność ozonatorów dostępnych na rynku, jest niezbyt precyzyjna, podatna na nadużycia i może łatwo wprowadzić nieświadomego użytkownika w błąd. Powoduje to brak zaufania do ozonu, jako skutecznego medium dezynfekcyjnego. Porównanie działania dostępnych na rynku ozonatorów szczegółowo zweryfikowaliśmy w ramach badań naukowych, a wyniki opisaliśmy w artykule „Badanie parametrów ozonatorów pod patronatem Polskiej Izby Gospodarczej Czystości.” W Ozonetube® stosujemy kilkukrotnie większe dawki ozonu, niż praktykuje to rynek. Każde ozonowanie osiąga u nas ponad 30 ppm. Rynkowym standardem jest od 2 do 8 ppm. Potwierdzeniem tego jest również fakt, że zdecydowana większość dostępnych na rynku mierników ozonu nie jest w stanie zmierzyć stężenia ozonowania naszych maszyn. Dlaczego? Bo standardowe mierniki lub detektory ozonu mierzą tylko stężenie do 10 ppm. Profesjonalny, odpowiednio skalibrowany miernik mierzy wyższe stężenia, nawet do 100 ppm. Bez tych pomiarów wysoka jakość usługi jest mało prawdopodobna, dlatego w Ozonetube® każde ozonowanie mierzymy i dokumentujemy skalibrowanym miernikiem. Ozonowanie hybrydowe™ to polska myśl technologiczna, gwarantująca potwierdzoną badaniami laboratoryjnymi skuteczność w dezynfekcji i usuwaniu zapachów, pleśni i jej zarodników. Na ozonowanie hybrydowe składa się wysokie stężenie ozonu, dedykowany roztwór, zamgławianie ULV oraz badania laboratoryjne. Ozonowanie hybrydowe jest bezpiecznym zbiegiem. Od lat przeprowadzamy go w wielu miejscach, nawet tych najbardziej wrażliwych, jak np. mleczarnie, czy chłodnie warzyw i owoców w marketach.
Ile kosztuje ozonowanie mieszkania?
Cena ozonowania zależy od wielkości lokalu, jego układu, ilości maszyn oraz od czasu, w którym pracują ozonatory. Zależy też od tego, co i gdzie usuwamy. Im większy jest zapach do usunięcia, tym dłuższej pracy maszyn potrzeba. Im większe mieszkanie czy dom oraz większa ilość pomieszczeń i zakamarków, tym więcej ozonatorów należy zastosować. Podam kilka przykładów:
Przykład 1: Usunięcie alergenów, zapachów, drobnoustrojów po zwierzętach
obiekt: mieszkanie 40 m kw. (Warszawa –Praga Południe)
cel: usunięcie drobnoustrojów po chorobie kota
ilość ozonetube®PRO: 2 szt.
czas zabiegu: 4 godz.
ilość osób: 1 cena: 980 zł netto
Przykład 2: Usunięcie zapachu papierosów, po poprzednich właścicielach, odświeżenie, dezynfekcja
obiekt: segment 150 m kw. (Legionowo)
cel: odświeżenie domu po poprzednim właścicielu
ilość ozonetube®PRO: 3 szt.
czas zabiegu: 3 godz.
ilość osób: 1
cena: 1 500 zł netto
Przykład 3: Usunięcie zapachów stęchlizny, zarodników pleśni, moli spożywczych
obiekt: mieszkanie 35 m kw. (Warszawa –Ursynów)
cel: dezaktywacja zarodników pleśni z powietrza
ilość ozonetube®PRO: 2 szt. czas zabiegu: 4 godz.
ilość osób: 1
cena: 1 250 zł netto
Przykład 4: Usunięcie zapachów po remoncie
obiekt: dom 250 m kw. (Konstancin)
cel: usunięcie alergenów po chemii budowlanej
ilość ozonetube™PRO: 6 szt. czas zabiegu: 7 godz.
ilość osób: 1
cena: 3 500 zł netto
Przykład 5: Usunięcie zapachów po pożarze kilka pięter niżej
obiekt: mieszkanie 55 m kw. (Warszawa Wola)
cel: usunięcie zapachów oraz szkodliwych związków lotnych po pożarze mieszkania sąsiada
ilość ozonetube®PRO: 2 szt.
czas zabiegu: 8 godz.
ilość osób: 1
cena: 2 000 zł netto
W celu uzyskania dokładnej wyceny przygotowaliśmy dedykowaną stronę >> https://www.ozonetube.pl/zamowusluge_formularz , gdzie można wypełnić formularz i uzyskać dokładną wycenę. Można również skontaktować się z Ozonetuberami telefonicznie lub mailowo w celu uzyskania szybkiej wyceny. Obecnie Ozonetube® buduje sieć franczyzową i wkrótce nasze ozonatory będą dostępne w wielu miejscach w Polsce (wypożyczalnie, firmy z branży DDD itd.), co wpłynie korzystnie na ich większą dostępność, a więc również na cenę usługi ozonowania.
Jak sprawdzić skuteczność ozonowania?
Badania laboratoryjne to dodatkowy koszt badania, którego zlecenie jest fakultatywne i decyduje o tym każdorazowo właściciel nieruchomości lub osoba, która go reprezentuje (agent, fliper itp.) Rozróżniamy badania laboratoryjne ilościowe w cenie od ~50-100 zł netto za próbkę i jakościowe w cenie od 600 zł netto za próbkę. U klienta, który chce zlecić badanie sugerujemy wykonanie minimum trzech próbek z lokalu i czwartej próbki z tła, czyli 4 próbki przed ozonowaniem i 4 próbki po ozonowaniu. Część klientów decyduje się też na próbki tylko po zabiegu. Badania nie są jednak obowiązkowe, bo pracując dla wielu sektorów gospodarki – również dla rynku nieruchomości - zlecaliśmy tysiące próbek i mamy przekrojową wiedzę w zakresie skuteczności zastosowania odpowiedniej liczby maszyn, w odpowiednim czasie, na odpowiedniej powierzchni. Ponadto, wielu klientów poza naszymi plecami zlecało badania laboratoryjne samodzielnie w wybranych przez siebie punktach w celu sprawdzenia efektów w niezależnym źródle. Wyniki te potwierdzały skuteczność i dzisiaj wielu klientom pokazując liczne rezultaty badań doradzamy rezygnowanie ze zlecania badań laboratoryjnych. Są one istotne we „wrażliwych branżach”, gdzie mamy do czynienia z produktami spożywczymi, mleczarskimi itd. W przypadku lokali mieszkalnych i domów nie jest to konieczne.
Dobry flipper musi kupić lokal tanio, sprawnie go odświeżyć i sprzedać szybko z jak najwyższą marżą. W tym działaniu istotny jest czas, aby zainwestowane pieniądze szybko odzyskać i móc realizować kolejne inwestycje. Owszem, niektórzy fliperzy obracają lokalami za pieniądze innych inwestorów, ale mechanizm działania jest taki sam. W związku z tym, że wiele mieszkań, czy domów przeznaczanych na sprzedaż nie podlega remontowi, fliperzy i agenci nieruchomości coraz chętniej sięgają po ozonowanie hybrydowe w celu uzyskania szybkiego efektu odświeżenia lokalu
w niskiej cenie. Ozonowanie to naturalny proces oczyszczania występujący w naturze - zjawisko występuje w czasie burzy w momencie, gdy piorun wytwarza ozon (potrójny tlen). Dzięki temu oczyszcza on powietrze, usuwa zapachy i dezynfekuje. Ozonetube®, każdego dnia przenosi to zjawisko przyrodnicze do wnętrz budynków – biur, sklepów, magazynów, a także wspomnianych mieszkań i domów na sprzedaż czy wynajem. Ozonowanie jest naturalną i skuteczną formą dezynfekcji i usuwania uciążliwych zapachów zwierząt, papierosów i stęchlizny. Usuwa także alergeny, grzyby, pleśnie
i bakterie. „Sucha burza” oczyszcza, zatem wnętrza nieruchomości, w których pracujemy i mieszkamy, dzięki czemu niskim kosztem, w ciągu kilku godzin możemy osiągnąć nową świeżość.
Jakie efekty daje ozonowanie mieszkania?
Fliperzy, agenci i pośrednicy nieruchomości coraz częściej korzystają
z ozonowania hybrydowego, żeby szybko i tanio pozbyć się śladów użytkowania pozostawionych przez poprzednich właścicieli, czy lokatorów. Dodam, że zapachy w mieszkaniach mogą być różne: od papierosów, od zwierząt (alergeny) od poprzednich lokatorów (starsi ludzie, a nawet menele). W ogłoszeniach lokali na sprzedaż czy wynajem, coraz częściej odnotowuje się czy w lokalu palono papierosy lub przebywały zwierzęta. Wiele osób jest uczulonych na sierść zwierząt, więc taki lokal automatycznie wypada z kręgu ich zainteresowań. Agenci opowiadali często, że wprowadzali potencjalnych kupujących do pustych od kilku lat mieszkań i zaczynali oni od razu kichać, mówiąc „tu był kot, nie będziemy tego oglądać” - i z transakcji nici. Zapach papierosów, albo zwierząt unoszący się w lokalu stanowi, zatem nierzadko problem w znalezieniu zainteresowanego nabywcy czy najemcy i jest to istotny czynnik przy sprzedaży lokali.
Remont to drogie rozwiązanie rzędu kilkudziesięciu tysięcy złotych, dlatego właściciele nieruchomości, fliperzy albo agenci nieruchomości nie decydują się na takie wydatki, jeśli nie muszą. Kilkukrotnie zdarzyło się nam usunąć zapach papierosów, który unosił się w mieszkaniu, w którym przeprowadzono remont! Nowe ściany, nowa farba i tapety, a nawet nowy pokój dla noworodka przeszły zapachem papierosów. Rodzice - nowi właściciele mieszkania byli zrozpaczeni.
Jak, zatem niskim kosztem usunąć przykre zapachy i drobnoustroje? Wysokie stężenie ozonu w ciągu kilku godzin potrafi usunąć nieprzyjemne zapachy
w sposób trwały. Nie jest to, zatem chwilowa „przykrywka” na czas sprzedaży lokalu. Co więcej, ozonowanie oprócz zapachów usuwa także bakterie, wirusy, a nawet grzyby! W związku z tym, da się wydezynfekować
i usunąć wszelkie elementy, które mogą utrudnić normalne funkcjonowanie nowemu nabywcy. Ozonowanie hybrydowe szybko daje efekt ogromnej świeżości - jest czysto pachnąco i świeżo w powietrzu. Ponadto, zastosowane ozonowanie przy sprzedaży lub wynajmie lokalu można przekłuć w atut. Jak? Przed i po każdym ozonowaniu jest możliwość pobrania próbek w celu laboratoryjnego przebadania skuteczności przeprowadzonego procesu. Ozonetube® wydaje certyfikaty potwierdzające ozonowanie i naklejki potwierdzające przeprowadzenie ozonowania w danym lokalu. Fliper lub agent może wykorzystać to, jako atut przy sprzedaży lokalu, przedstawiając kupującemu wyniki badań i certyfikat ozonowania hybrydowego™. A co z pokojem noworodka? Zespół Ozonetube® usunął zapach papierosów
w wyremontowanym mieszkaniu trwale już w 12 godz.
Po co ozonować lokal na sprzedaż?
Kamil Krupicz z agencji nieruchomości Wood&Stone postanowił w celu odświeżenia mieszkania zlecić ozonowanie w jednym z mieszkań w bloku na Sadybie. Obecny właściciel posiadał koty, a dla Kamila istotne było, żeby nowy kupujący obejrzał sobie mieszkanie w komfortowych warunkach i nie wyczuł, że mieszkały tu również zwierzęta. Ściany w 3 pokojach były w tapecie i boazerii, a wszystkie te zapachy weszły w struktury okładzin. Remont mieszkania, wymiana tapet, ściągniecie boazerii i malowanie ścian nie wchodziły w grę, bo wymagałoby to zbyt dużych nakładów finansowych.
Agent zdecydował się na ozonowanie hybrydowe z Ozonetube®. Dodatkowo, zostawiliśmy otwarte drzwi od lodówki, w celu wywietrzenia i dezynfekcji jej wnętrza. Kamil po ozonowaniu stwierdził, że czystość powietrza faktycznie była jak po porannej burzy. Nie było przykrych zapachów i naprawdę czuć było świeżość – zarówno w mieszkaniu, jak i w lodówce. Gdy przychodzili potencjalni kupujący nie mówili nic na temat przykrych zapachów, a mieszkanie sprzedało się w ciągu tygodnia. Poniżej możecie obejrzeć rozmowę z Kamilem Krupiczem z Wood & Stone.
Czy ozonowanie mieszkania jest bezpieczne?
Po okresie pandemii ozonowanie, podobnie jak dozowniki z płynem do dezynfekcji rąk, zostało na stałe w wielu sektorach gospodarki, jako standard. W branży nieruchomości przykładowo przeprowadza się je w hotelach, domkach letniskowych, i to każdorazowo po każdym gościu! Wiele osób pyta czy ozonowanie jest bezpieczne?
A inna część osób uważa, że ozonowanie nie działa. Jeżeli robi się to zbyt małą mocą, to może nie być żadnego efektu lub może być on symboliczny. Wyobraźmy sobie, że chcielibyśmy ugotować zupę w garnku podgrzewanym ogniem z zapalniczki - też doszlibyśmy do wniosku, że ogień nie działa. Ozonowanie działa, jeśli proces przeprowadzi się z właściwą mocą ozonu i odpowiednio długo się ją utrzyma. Dobrze przeprowadzony zabieg jest skuteczny i bezpieczny!
Najpopularniejszym i zarazem najbardziej zwodniczym współczynnikiem jest określanie wydajności ozonatorów w gramach na godzinę (g/h) produkowanego ozonu. Parametr ten ze względu na niestabilną naturę ozonu jest w zasadzie niemożliwy do bezpośredniego zmierzenia i może zostać jedynie oszacowany na podstawie stężenia ozonu w strumieniu powietrza wylatującego z ozonatora. Tak zdefiniowana wielkość, będąca głównym
i często jedynym parametrem opisującym wydajność ozonatorów dostępnych na rynku, jest niezbyt precyzyjna, podatna na nadużycia i może łatwo wprowadzić nieświadomego użytkownika w błąd. Powoduje to brak zaufania do ozonu, jako skutecznego medium dezynfekcyjnego. Porównanie działania dostępnych na rynku ozonatorów zostało szczegółowo zweryfikowane w ramach badań naukowych, a wyniki zostały opisane w artykule „Badanie parametrów ozonatorów pod patronatem Polskiej Izby Gospodarczej Czystości.”
W Ozonetube® stosujemy kilkukrotnie większe dawki ozonu, niż praktykuje to rynek. Każde ozonowanie osiąga u nas ponad 30 ppm. Rynkowym standardem jest od 2 do 8 ppm. Potwierdzeniem tego jest również fakt, że zdecydowana większość dostępnych na rynku mierników ozonu nie jest w stanie zmierzyć stężenia ozonowania naszych maszyn. Dlaczego? Bo standardowe mierniki lub detektory ozonu mierzą tylko stężenie do 10 ppm. Profesjonalny, odpowiednio skalibrowany miernik mierzy wyższe stężenia, nawet do 100 ppm. Bez tych pomiarów wysoka jakość usługi jest mało prawdopodobna, dlatego w Ozonetube® każde ozonowanie mierzymy i dokumentujemy skalibrowanym miernikiem.
Ozonowanie hybrydowe™ to polska myśl technologiczna, gwarantująca potwierdzoną badaniami laboratoryjnymi skuteczność w dezynfekcji i usuwaniu zapachów, pleśni i jej zarodników. Na ozonowanie hybrydowe składa się wysokie stężenie ozonu, dedykowany roztwór, zamgławianie ULV oraz badania laboratoryjne. Ozonowanie hybrydowe jest bezpiecznym zbiegiem. Od lat przeprowadzamy go w wielu miejscach, nawet tych najbardziej wrażliwych, jak np. mleczarnie, czy chłodnie warzyw i owoców w marketach.
Ile kosztuje ozonowanie mieszkania?
Cena ozonowania zależy od wielkości lokalu, jego układu, ilości maszyn oraz od czasu, w którym pracują ozonatory. Zależy też od tego, co i gdzie usuwamy. Im większy jest zapach do usunięcia, tym dłuższej pracy maszyn potrzeba. Im większe mieszkanie czy dom oraz większa ilość pomieszczeń i zakamarków, tym więcej ozonatorów należy zastosować. Podam kilka przykładów:
Przykład 1: Usunięcie alergenów, zapachów, drobnoustrojów po zwierzętach
obiekt: mieszkanie 40 m kw. (Warszawa –Praga Południe)
cel: usunięcie drobnoustrojów po chorobie kota
ilość ozonetube®PRO: 2 szt.
czas zabiegu: 4 godz.
ilość osób: 1 cena: 980 zł netto
Przykład 2: Usunięcie zapachu papierosów, po poprzednich właścicielach, odświeżenie, dezynfekcja
obiekt: segment 150 m kw. (Legionowo)
cel: odświeżenie domu po poprzednim właścicielu
ilość ozonetube®PRO: 3 szt.
czas zabiegu: 3 godz.
ilość osób: 1
cena: 1 500 zł netto
Przykład 3: Usunięcie zapachów stęchlizny, zarodników pleśni, moli spożywczych
obiekt: mieszkanie 35 m kw. (Warszawa –Ursynów)
cel: dezaktywacja zarodników pleśni z powietrza
ilość ozonetube®PRO: 2 szt. czas zabiegu: 4 godz.
ilość osób: 1
cena: 1 250 zł netto
Przykład 4: Usunięcie zapachów po remoncie
obiekt: dom 250 m kw. (Konstancin)
cel: usunięcie alergenów po chemii budowlanej
ilość ozonetube™PRO: 6 szt. czas zabiegu: 7 godz.
ilość osób: 1
cena: 3 500 zł netto
Przykład 5: Usunięcie zapachów po pożarze kilka pięter niżej
obiekt: mieszkanie 55 m kw. (Warszawa Wola)
cel: usunięcie zapachów oraz szkodliwych związków lotnych po pożarze mieszkania sąsiada
ilość ozonetube®PRO: 2 szt.
czas zabiegu: 8 godz.
ilość osób: 1
cena: 2 000 zł netto
W celu uzyskania dokładnej wyceny przygotowaliśmy dedykowaną stronę >> https://www.ozonetube.pl/zamowusluge_formularz , gdzie można wypełnić formularz i uzyskać dokładną wycenę. Można również skontaktować się z Ozonetuberami telefonicznie lub mailowo w celu uzyskania szybkiej wyceny. Obecnie Ozonetube® buduje sieć franczyzową i wkrótce nasze ozonatory będą dostępne w wielu miejscach w Polsce (wypożyczalnie, firmy z branży DDD itd.), co wpłynie korzystnie na ich większą dostępność, a więc również na cenę usługi ozonowania.
Jak sprawdzić skuteczność ozonowania?
Badania laboratoryjne to dodatkowy koszt badania, którego zlecenie jest fakultatywne i decyduje o tym każdorazowo właściciel nieruchomości lub osoba, która go reprezentuje (agent, fliper itp.) Rozróżniamy badania laboratoryjne ilościowe w cenie od ~50-100 zł netto za próbkę i jakościowe w cenie od 600 zł netto za próbkę. U klienta, który chce zlecić badanie sugerujemy wykonanie minimum trzech próbek z lokalu i czwartej próbki z tła, czyli 4 próbki przed ozonowaniem
i 4 próbki po ozonowaniu. Część klientów decyduje się też na próbki tylko po zabiegu.
Badania nie są jednak obowiązkowe, bo pracując dla wielu sektorów gospodarki – również dla rynku nieruchomości - zlecaliśmy tysiące próbek i mamy przekrojową wiedzę w zakresie skuteczności zastosowania odpowiedniej liczby maszyn, w odpowiednim czasie, na odpowiedniej powierzchni. Ponadto, wielu klientów poza naszymi plecami zlecało badania laboratoryjne samodzielnie w wybranych przez siebie punktach w celu sprawdzenia efektów w niezależnym źródle. Wyniki te potwierdzały skuteczność i dzisiaj wielu klientom pokazując liczne rezultaty badań doradzamy rezygnowanie ze zlecania badań laboratoryjnych. Są one istotne we „wrażliwych branżach”, gdzie mamy do czynienia z produktami spożywczymi, mleczarskimi itd. W przypadku lokali mieszkalnych i domów nie jest to konieczne.
Czy wiesz, jakie są możliwości influencer marketingu?
Czy znasz sposoby dotarcia do nowych ambasadorów marki?
Czy współpraca marek i influencerów jest opłacalna?
Nawiąż partnerstwo z See Bloggers Łódź i zwiększ zasięgi oraz rozpoznawalność marki.
See Bloggers Łódź to największy festiwal dla twórców internetowych w Polsce. Celem wydarzenia jest edukacja oraz integracja środowiska influencerów i biznesu. Marki dowiadują się, jak rozpocząć, doskonalić i rozwijać współpracę z blogerami, youtuberami, czy instagramerami, a influencerzy, jak efektywnie gromadzić aktywną społeczność i tworzyć skuteczne kampanie marketingowe. W tym roku dla Partnerów festiwalu przygotowaliśmy dedykowane prelekcje, panele i warsztaty na Scenie Edukacyjnej! Wiedzę z tych aktywności marki będą mogły wykorzystać w doskonaleniu współpracy z influencerami oraz w aktywności w social mediach.
Marka ozonetube® jest własnością Driving Centers Sp. z o.o. z siedzibą w Warszawie,
ul. Domaniewska 47/10, 02-672 Warszawa, wpisana do rejestru przedsiębiorców pod numerem KRS: 0000422858,
kapitał zakładowy w wysokości 5.000,00 zł (słownie: pięć tysięcy złotych), REGON: 146157501, NIP: PL7010344905.